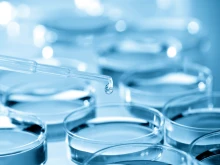

Monday, January 19, 2026
Monday, January 19, 2026
Embryo
The Latest
Alabama Supreme Court rules that frozen embryos are children under state law
State's wrongful death act applies to all children "regardless of their location." Read more
Catholic columnist: ‘Brave new world’ of embryo experimentation could sharpen Communion debate
Recent developments regarding experimentation on human embryos could force a larger conflict between Catholic Democratic politicians and U.S. bishops on... Read more
‘Utter disregard’ for life: Members of Congress slam new guidance on embryo research
Two members of Congress this week criticized new guidance by a leading scientific organization removing prohibitions on research of human... Read more
Research on human embryos in an artificial womb? Why recent experiments have ethicists concerned
After scientists successfully grew mouse embryos in an artificial uterus, ethicists are warning against any future extension of the experiments... Read more
Chinese scientists, officials denounce gene-editing of embryos
A Chinese scientist’s claim to have created a gene-edited baby has been met with an outpouring of condemnation, with critics... Read more